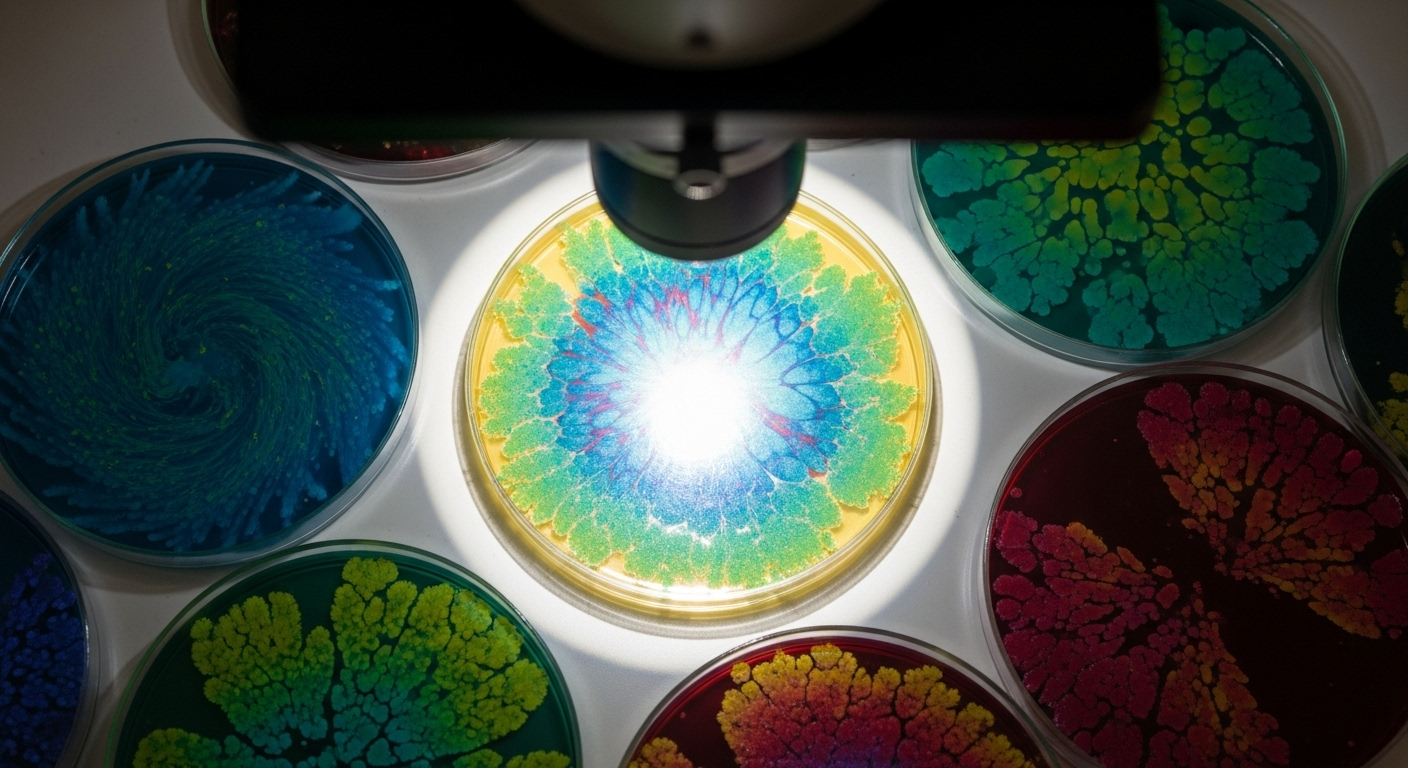

Un gène des supercentenaires protège le cœur d’enfants atteints d’une maladie du vieillissement accéléré
Auteur: Adam David
le paradoxe d’une vie trop courte et d’une vie sans fin
Et si le secret de la très grande longévité pouvait soigner une maladie qui, à l’inverse, accélère le temps ? C’est la piste fascinante explorée par des chercheurs italiens et britanniques. Ils ont découvert qu’un gène, que l’on retrouve chez des centenaires en parfaite santé, pourrait protéger le cœur des enfants atteints de progéria, cette maladie rare qui les fait vieillir à une vitesse effroyable.
La progéria, une course contre le temps inscrite dans les gènes
Le syndrome de Hutchinson-Gilford, plus connu sous le nom de progéria, est une maladie aussi rare qu’implacable. Elle tire son origine d’une minuscule erreur dans le gène LMNA, qui fabrique normalement une protéine essentielle à la structure de nos noyaux cellulaires. Chez ces enfants, la mutation produit une version toxique, la progérine, qui s’entasse dans les cellules et dérègle toute la machine.
Les conséquences sont visibles dès la petite enfance : la croissance s’arrête, les cheveux tombent, les articulations se raidissent. Mais le véritable ennemi, c’est le vieillissement cardiovasculaire accéléré. Le cœur se rigidifie, n’arrive plus à se remplir correctement, et finit par lâcher. La plupart des enfants ne dépassent pas l’âge de 15 ans. L’histoire de l’Italien Sammy Basso, qui a lutté jusqu’à 28 ans, reste une exception poignante.
Un traitement existe, le lonafarnib, qui ralentit la production de progérine. Mais il ne répare pas les dégâts déjà là, surtout au niveau du cœur. C’est cette impasse qui a poussé les scientifiques à chercher une solution ailleurs.

Le secret niché dans l’ADN des centenaires
Le raisonnement des chercheurs est parti d’un constat simple. Comment se fait-il que certaines personnes, les « super-centenaires », dépassent les 100 ans avec un système cardiovasculaire encore étonnamment vaillant ? En fouillant leur ADN, on avait déjà identifié un variant génétique particulier : LAV-BPIFB4. Un nom barbare pour un gène qui semble être un véritable bouclier pour les vaisseaux sanguins.
L’idée, audacieuse, était née : et si ce gène de la longévité pouvait contrer les effets d’une maladie du vieillissement accéléré ? Pour le vérifier, l’équipe a monté une expérience cruciale, dont les résultats viennent d’être publiés dans la revue Signal Transduction and Targeted Therapy.
L’expérience sur les souris : une protection inattendue du cœur
Les scientifiques ont d’abord travaillé sur des souris génétiquement modifiées pour produire la progérine humaine. Comme les enfants, ces animaux développent très vite des problèmes cardiaques, notamment une rigidité du muscle qui peine à se détendre. C’est ce qu’on appelle une dysfonction diastolique.
Ils ont alors fait une seule injection du gène « de longévité », transporté par un virus rendu inoffensif qui agit comme un vecteur. Les résultats, deux mois plus tard, ont dépassé leurs attentes. La fonction cardiaque des souris traitées s’était nettement améliorée. Leur cœur avait retrouvé de la souplesse. C’était la preuve que le concept fonctionnait.
Comment ça marche ? Renforcer les défenses plutôt qu’attaquer la cause
Le plus surprenant, c’est que le gène LAV-BPIFB4 ne s’attaque pas directement à la progérine. Il ne la fait pas disparaître. Son action est plus subtile. Il agit comme un chef d’orchestre qui renforce les défenses naturelles de la cellule face à l’agression.
Concrètement, il a réduit la fibrose, cette accumulation de tissus rigides qui « étouffe » le cœur. Il a aussi favorisé la création de nouveaux petits vaisseaux sanguins et diminué le nombre de cellules « sénescentes », ces cellules zombies qui entretiennent l’inflammation et le vieillissement. En somme, il ne supprime pas le poison, mais il donne au corps les armes pour lui résister.
De la souris à l’humain : des tests en labo qui confirment la piste
Pour s’assurer que cette découverte n’était pas limitée aux souris, l’équipe a ensuite travaillé sur des cellules humaines, prélevées sur des patients atteints de progéria. Le verdict est sans appel. Dans ces cellules malades, l’expression du gène BPIFB4 normal était très faible, comme si la maladie elle-même l’éteignait.
En introduisant artificiellement le variant « de longévité », les chercheurs ont vu les marqueurs du vieillissement cellulaire chuter. Les cellules produisaient moins de collagène et d’autres protéines qui rigidifient les tissus. Cela confirme que le mécanisme de protection pourrait bien être transposable à l’humain.

vers une nouvelle philosophie du traitement du vieillissement ?
Cette avancée ouvre bien plus qu’une simple porte pour la progéria. Elle esquisse une nouvelle manière de penser les traitements contre le vieillissement, qu’il soit pathologique ou naturel. Plutôt que de chercher à éliminer chaque cause une par une, on pourrait s’inspirer des champions de la longévité pour renforcer la résilience globale de notre organisme.
Les chercheurs imaginent déjà des applications pour l’insuffisance cardiaque commune chez les personnes âgées. Et si la thérapie génique par virus semble complexe, surtout chez l’enfant, d’autres voies sont explorées, comme l’ARN messager ou des nanoparticules. L’idée de puiser dans le code génétique de ceux qui vivent le plus longtemps pour soigner ceux dont la vie est menacée par le temps qui passe n’est plus de la science-fiction. C’est peut-être l’un des visages de la médecine de demain.